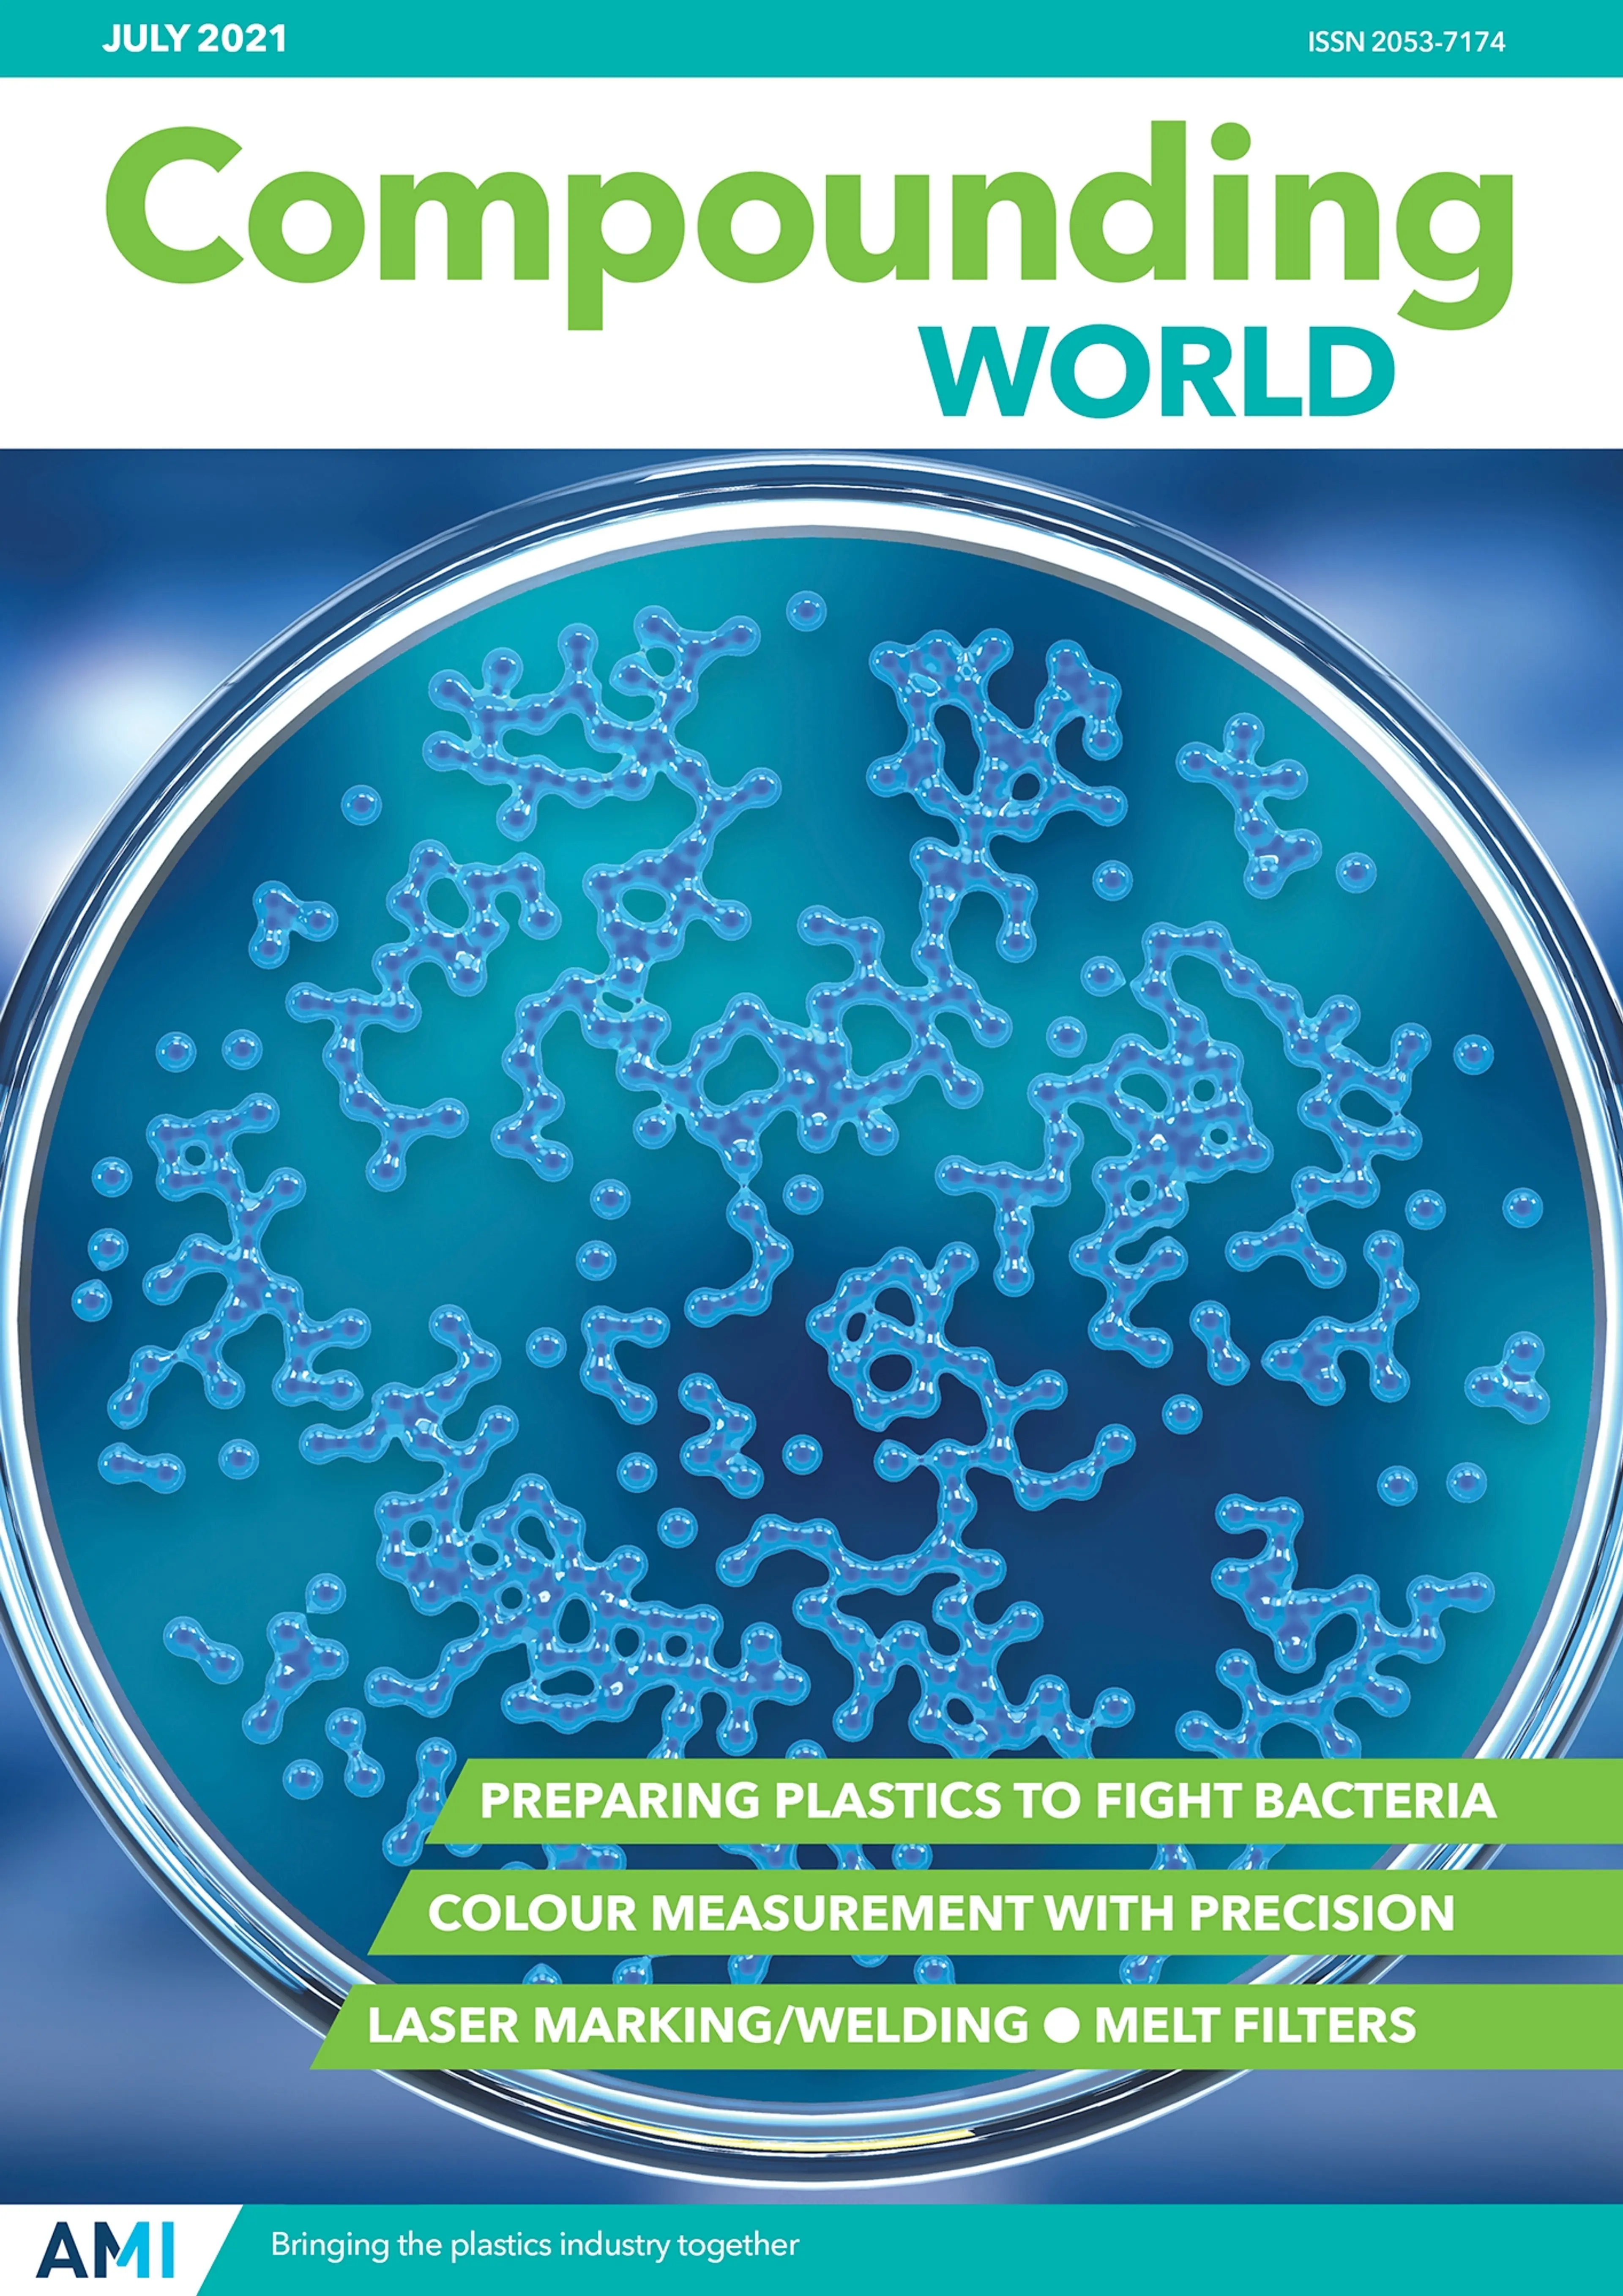

Access past issues of Compounding World free of charge
Archive Issues
2025
November 2025 
Featuring:
- News from K2025
- Battling challenges in black and white
- Widening scope for bioplastic materials
- Finding health in vinyls recycling sector
- Making advances in mixing technology
October 2025 
Featuring:
- Graphene and CNTs hit the market
- K2025 Show Preview
- Additives aim to complete the circle
- Processing with alternative technologies
- Preview: Compounding World Expo
September 2025 
Featuring:
- Colour impact: suppliers boost offerings
- K 2025 Show Preview
- UV stabilisers strengthen sustainability
- Taking the heat away
- Thermal boost: high temperature plastics
August 2025 
Featuring:
- AI makes its way into compounding
- Meeting the demands of EV applications
- New options for making PVC flexible
- K2025: ready for launch
July 2025 
Featuring:
- Fighting microbes to make plastics durable
- Efficiency is the keyword for material flows
- Capturing consistency in colour matching
- New ways to combat volatile off-gases
June 2025 
Featuring:
- New mineral and alternative fillers
- Turning to recycled fibres for compounds
- Additives deal with PVC challenges
- New filters cope with contamination
May 2025 
Featuring:
- Natural fillers reduce carbon footprint
- Rethinking wire and cable
- Amazon’s vision for bioplastics packaging
- Forming a bond: new compatibilisers
- The choice of materials expands in 3DP
April 2025 
Featuring:
- Process aids: Smoothing the surface
- Medical-grade compounds fit the bill
- RACE Recycling and Compounding Expo
- Engineering toughness: new impact solutions
- Enhancing performance in polyamides
March 2025 
Featuring:
- Adding intelligence to extruder technology
- Achieving the right effect
- Advances in materials analysis technology
- LFTs expand further in auto applications
January/February 2025 
Featuring:
- Breaking through: additives for films
- Protective plastics in electrical settings
- Advancements in pelletising systems
2024
December 2024 
Featuring:
- Insights from masterbatch market experts
- Pressure proliferate in flame retardants
- Researching innovation at a small scale
- Distributors increase profits in harsh market
November 2024 
Featuring:
- Emerging bioplastics perform better
- Commitment to recycling continues in PVC
- Looking for answers in black and white
- Moving ahead in mixing
- TaipeiPLAS: Taiwan’s plastics showcase
October 2024 
Featuring:
- Nanocomposites expand application base
- Finding the right alternative (compounding technologies)
- Let’s go round again: recycling additives
- Preview: Compounding World Expo
- Preview: Fakuma 2024
September 2024 
Featuring:
- The development of pigments with purpose
- Stabiliser products target plasticulture
- Cooling materials for a hotter world
- Thermoplastics take on the extremes
August 2024 
Featuring:
- Taking control with in-line measurement
- Sustainable solutions for flexible PVC
- Compounds for cars of today and tomorrow
- Brussels hosts Compounding World Expo
July 2024 
Featuring:
- Meeting the odour challenge head on
- Feeding the need for compounding efficiency
- Antimicrobials deal with safety and regulation
- Making strides in colour management
June 2024 
Featuring:
- Fibres reinforce sustainability trend
- PVC additive evolve still further
- Reducing cost and carbon
- Melt filtration moves in new directions
May 2024 
Featuring:
- Earth story: natural fibres and fillers
- Shaping new materials to applications
- Unravelling the potential in wire and cable
- Bringing together dissimilar materials
- NPE 2024 Preview
April 2024 
Featuring:
- Innovations in compounds for medical applications
- The benefits of processing aid and lubricant additives
- New polyamide additives
- Options for impact modification
March 2024 
Featuring:
- LFTs rise to the challenge
- Twin screw extruder developments
- Making plastics look special
- Putting materials to the test
January/February 2024 
Featuring:
- Additives for performance films
- Innovation in pelletising systems
- Electrically conductive compounds
- Chemical Recycling Global Insight 2024
2023
December 2023 
Featuring:
- Regulation shapes flame retardant development
- Polymer taggants beat the fakers
- Mixing it up in the laboratory
- Compounders find the urge to purge
October 2023 
Featuring:
- Nanocomposites
- Recycling additives
- Alternative compounders
- Compounding World Expo
- Fakuma preview
September 2023 
Featuring:
- Thermally conductive plastics
- Colour pigments
- Accelerated testing
- Stabilers and AOs
2022
December 2022 
Featuring:
- Flame retardants
- Lab trial pointers
- Lab compounders
- Anti-counterfeiting
- K2022 review
November 2022 
Featuring:
- Black and white pigments
- Batch mixers
- High performance compounds
- Inline measurement
October 2022 
Featuring:
- Nanocomposites
- K2022 preview: Machinery
- Recycling additives
- Alternative compounders
- Compounding World Expo US
September 2022 
Featuring:
- Colour pigments
- K2022 Materials Preview
- Bioplastics
- AOs and stabilisers
- CWE conference preview
August 2022 
Featuring:
- Thermally conductive additives
- PVC plasticisers
- Process control
- Wood plastic composites
- K2022 visitor guide
February 2022 
Featuring:
- Electrically conductive plastics
- Surface modification
- PA additives
- IMDE conference preview
2021
October 2021 
Featuring:
- Nanocomposites
- Alternative compounders
- Compounding World Expo USA
- Recycling additives
- Fakuma 2021 preview
September 2021 
Featuring:
- Bioplastics
- Pigments
- Purging and cleaning
- Stabilisers and antioxidants
- Compounding World Expo
April 2021 
Featuring:
- Compounds for EVs
- Impact modifiers
- Small batch compounding
- Chinaplas preview
- Process aids
February 2021 
Featuring:
- Energy management
- Electrically conductive plastics
- Friction and wear
- PA additives
2020
October 2020 
Featuring:
- Recycling additives
- Alternative compounders
- Titanium dioxide
- Performance polymers
August 2020 
Featuring:
- PVC plasticisers
- Covid-19 market impact
- Conductive plastics
- Industry 4.0
- Screws and barrels
June 2020 
Featuring:
- PVC stabilisers
- Functional fillers
- Nucleators and clarifiers
- Wood-plastic composites
March 2020 
Featuring:
- Simulation
- Twin screw extruders
- LFT developments
- Artificial intelligence
- Odour and emissions
2019
December 2019 
Featuring:
- Nanocomposites
- Lab compounders
- Flame retardants
- Accelerated testing
- K2019 show review
October 2019 
Featuring:
- Titanium dioxide
- 3D printing
- Recycling additives
- K2019 preview: Machinery
- Alternative compounders
August 2019 
Featuring:
- PVC plasticisers
- Reactive compounding
- K2019 visitor guide
- Wood plastic composites
- Screws and barrels
July 2019 
Featuring:
- Antimicrobials
- Melt filters
- Colour measurement
- Dosing and feeding
- Compounding World Asia
June 2019 
Featuring:
- Clarifiers and nucleators
- Compounding World Expo
- Functional fillers
- PVC additives
- Clean compounding
May 2019 
Featuring:
- Plant management
- Compatibilisers
- Wire and cable
- Chinaplas preview
- High density compounds
April 2019 
Featuring:
- CWE show preview
- Thermally conductive
- PPS compounds
- Processing aids
- Materials testing
March 2019 
Featuring:
- Effect pigments
- Natural fibres
- LFT production
- Process simulation
- Twin screw extruders
February 2019 
Featuring:
- PA additives
- Surface modification
- Electrically conductive
- Materials handling
- PVC Formulation
2018
December 2018 
Featuring:
- Nanocomposites
- Lab compounders
- Flame retardants
- 10th anniversary edition
- Weather testing
October 2018 
Featuring:
- Alternative compounders
- Titanium dioxide
- Fakuma preview
- 3D print materials
- Reinforcements
September 2018 
Featuring:
- Pigments and colorants
- Reactive compounding
- Polymer stabilisers
- Recycling additives
- Supply chain
August 2018 
Featuring:
- PVC plasticisers
- Dosing and feeding
- Functional fillers
- Screws and barrels
- Compounding World Expo
April 2018 
Featuring:
- Thermally conductive compounds
- Extruder maintenance
- Chinaplas preview
- Processing aids
- Polymer testing
March 2018 
Featuring:
- Process simulation
- Twin screw extruders
- Natural fibres
- Effect pigments
- Product design
February 2018 
Featuring:
- Electrical conductive plastics
- Polyamide additives
- Bulk materials handling
- Laser additives
January 2018 
Featuring:
- Pelletiser developments
- Odour and emissions
- Film additives
- Polymer foaming
- PVC Formulation 2018
2017
December 2017 
Featuring:
- Anti-counterfeiting
- Lab compounders
- Flame retardants
- Weather testing
- UV stabilisers
November 2017 
Featuring:
- Batch/continuous mixers
- Carbon black update
- Fakuma 2017 review
- Surface modification
- Colour masterbatch
October 2017 
Featuring:
- Titanium dioxide
- Reinforcing fibres
- Fakuma preview
- Smart packaging
- Polymers in Footwear
September 2017 
Featuring:
- Reactive extrusion
- Antioxidants and stabilisers
- Pigments
- Materials testing
- Event preview
August 2017 
Featuring:
- Performance PP
- PVC plasticisers
- Functional fillers
- Wear mangement
- Compounding World Asia
July 2017 
Featuring:
- Melt filtration
- Measuring colour
- Colour instrumentation
- Impact modifiers
- Antimicrobials
May 2017 
Featuring:
- Wire and cable
- Industry 4.0
- Clarifiers and nucleators
- Chinaplas preview
- Market analysis
April 2017 
Featuring:
- Extruder maintenance
- Conductive plastics
- Recycling additives
- Purging compounds
- Engineering plastics
March 2017 
Featuring:
- Natural fibres
- Computer simulation
- Twin screw extruders
- Special effect pigments
- Compounding World Congress
February 2017 
Featuring:
- Thermally conductive plastics
- Additives for PA
- Materials handling
- Laser marking
- Compounding World Congress
January 2017 
Featuring:
- Odour and emissions
- Pelletising technology
- Film additives
- Foamed plastics
- CWF 2016 in review
2016
December 2016 
Featuring:
- Flame retardants
- Fire testing
- Anti-counterfeiting
- Lab compounders
- K2016 show review
November 2016 
Featuring:
- Surface modification
- K2016 show news
- Carbon black
- Batch mixing
- Conductive plastics
October 2016 
Featuring:
- Fibre reinforcements
- Active packaging
- Titanium dioxide
- K2016 machinery preview
- In-line compounding
September 2016 
Featuring:
- Pigment developments
- Antioxidants and stabilisers
- Materials testing
- Carbon nanotubes
- K2016 materials preview
August 2016 
Featuring:
- PVC plasticisers
- Functional fillers
- Managing wear
- K2016 visitor guide
- Electrical & electronic
July 2016 
Featuring:
- Antimicrobials
- Impact modifiers
- Colour measurement
- Melt filtration
- Automotive applications
June 2016 
Featuring:
- Multi-screw compounders
- PVC additives
- Bioplastic compounds
- Chinaplas review
- WPC innovations
May 2016 
Featuring:
- Nucleators and clarifiers
- Polymers for 3D printing
- LFT technologies
- Wire and cable
- Engineering plastics
April 2016 
Featuring:
- Recycling additives
- Clean compounding
- Conductive plastics
- Chinaplas preview
- CWC 2016
March 2016 
Featuring:
- Twin screw extruders
- Polyketone polymers
- Natural fibres
- High density compounds
- Engineeering plastics
February 2016 
Featuring:
- Thermally conductive addtives
- Performance polyamides
- Managing scratch and mar
- Conductive compounds
- Materials handling
January 2016 
Featuring:
- Film additives
- Pelletizing technology
- Polymer foams
- Purging compounds
- Compounding World Forum
2015
December 2015 
Featuring:
- Flame retardants
- Laboratory compounders
- Anti-counterfeiting additives
- Polymer distribution
- Latin American markets
November 2015 
Featuring:
- Surface modification
- Fakuma 2015 review
- Carbon black
- Mixing technology
- Compounding World Forum
October 2015 
Featuring:
- TiO2 markets
- Reinforcing fibres
- Pellet sorting
- High temperature plastics
- Fakuma preview
September 2015 
Featuring:
- What's new in pigments
- Machinery markets
- Polymer stabilisation
- Testing and characterisation
- Sustainability
August 2015 
Featuring:
- Making the most of minerals
- What's new in kneaders
- PVC plasticizers go green
- New applications for magnetite
- European market analysis
- Compounding World Asia preview
July 2015 
Featuring:
- The latest antimicrobial additives
- Monitoring colours in plastics
- Advances in melt filtration
- Enhancing engineering plastics
- Discussing new materials in Asia
June 2015 
Featuring:
- Selecting stabilizers for PVC
- Raising the performance of PLA
- Electrical & electronic applications
- Measuring weather resistance
- The latest machinery from Italy
- Compounding World Asia preview
May 2015 
Featuring:
- Producing plastics for 3D printing
- New wire and cable compounds
- Clarifying and nucleating agents
- Exploring conductive plastics
- Chinaplas 2015: show highlights
April 2015 
Featuring:
- Additives revive recycled plastics
- Electrically-conductive plastics
- Advances in reactive extrusion
- Recycled plastics for car interiors
- Plast 2015: Milan show preview
- Compounding news from NPE
March 2015 
Featuring:
- Selecting special effect pigments
- Twin-screws turn up the torque
- Natural fibres for auto parts
- The compounders' guide to NPE
- CWC Cologne exhibition preview
February 2015 
Featuring:
- Thermally-conductive compounds
- NPE 2015: machinery highlights
- Advances in computer simulation
- New materials handling systems
- Polyketones make a comeback
- Compounding World Congress
- What's behind Citroën's Airbump?
January 2015 
Featuring:
- Focus on foaming agents
- The latest pelletizing systems
- Additives for making better films
- Philadelphia Forum review
- PlastIndia 2015 preview
- Cologne Congress preview
2014
December 2014 
Featuring:
- The latest flame retardants
- Additives for laser marking
- New lab-scale compounders
- Renewably-resourced plastics
- Mergers and acquisitions
November 2014 
Featuring:
- Anti-counterfeiting additives
- Controlling electrical conductivity
- Carbon blacks that are green
- Global polymer demand trends
- The latest mixing systems
- Compounding World Forum
October 2014 
Featuring:
- New fibres for added strength
- Trends in titanium dioxide
- Thermoplastic elastomers
- Fakuma 2014 show highlights
- Using food waste as fillers
- Compounding World Forum
September 2014 
Featuring:
- Adding colour to thermoplastics
- Taking halogens out of pigments
- Optimising extruder venting
- Antioxidants and UV stabilizers
- Testing polymer properties
- Compounding World Forum
August 2014 
Featuring:
- PVC plasticizer developments
- The latest functional fillers
- Seeking compound compatibility
- Africa's growing plastics market
- Analysing plastic pellet quality
July 2014 
Featuring:
- Antimicrobial additives
- Faster formulations
- Melt filtration systems
- Colour measurement
- Automotive market trends
- Compounding World Forum
June 2014 
Featuring:
- Making better bioplastics
- The latest PVC stabilizers
- Measuring weatherability
- High-temperature plastics
- Putting vinyl to the test
May 2014 
Featuring:
- Photoluminescent pigments
- Adding electrical conductivity
- New clarifiers and nucleators
- Meeting REACH requirements
- Engineering thermoplastics
- Predicting the next colour trends
- News from Chinaplas 2014
April 2014 
Featuring:
- Additives revive recycled plastics
- Europe's biggest compounders
- The return of vinyl records
- New wire and cable technologies
- Chinaplas exhibition preview
March 2014 
Featuring:
- Growing natural fibre markets
- The latest twin-screw extruders
- How to improve biopolymers
- Additives give a boost to PET
- Tips for energy-efficient extrusion
February 2014 
Featuring:
- The future for nanocomposites
- Thermally-conductive plastics
- New additives for polyolefins
- Improve your materials handling
- Latest long fibre thermoplastics
January 2014 
Featuring:
- Picking the perfect pelletizer
- Creating foamed polymers
- New developments in additives
- Compounding World Forum
- A fresh approach to foaming PP
2013
December 2013 
Featuring:
- Fighting fires in plastics
- The latest lab compounders
- Focus on E&E applications
- European markets trends
- K 2013: machinery review
November 2013 
Featuring:
- Safety tips for compounders
- Make the most of carbon black
- What's new in batch mixers
- Industry news from K 2013
- CWF 2013: exhibition preview
October 2013 
Featuring:
- The compounders' guide to K
- The latest fibre reinforcements
- New trends in titanium dioxide
- Opening up opportunities in India
- PolyOne gets closer to designers
September 2013 
Featuring:
- Picking pigments for plastics
- Measuring melt properties
- Boosting bioplastics properties
- K 2013: materials preview
- Compounding World Forum 2013
- Degradables debate continues
August 2013 
Featuring:
- Play it safe: new PVC plasticizers
- The debate about degradables
- Adding value with functional fillers
- K 2013 - get ready for showtime
- Compounding World Forum news
July 2013 
Featuring:
- Understanding how colour works
- Online monitoring of colour
- Antimicrobial additives in action
- The latest trends in TPEs
- Focus on melt filtration systems
June 2013 
Featuring:
- Developments in PVC stabilizers
- Compounding better bioplastics
- Raising the bar for recycled PP
- Reliable testing of weatherability
- Clariant looks to eastern Europe
May 2013 
Featuring:
- Electrically-conductive plastics
- Clarifiers and processing aids
- Wood-plastic composites (WPCs)
- Chinaplas 2013 show preview
April 2013 
Featuring:
- Sustainable compounding
- Wire and cable applications
- What's new in antioxidants?
- Troubleshooting pellet defects
- Celebrating our 50th issue
March 2013 
Featuring:
- Additives boost PET performance
- The latest twin-screw extruders
- Trends in polymer distribution
- Going green with natural fibres
- PolyOne reveals colour forecasts
February 2013 
Featuring:
- Thermally-conductive plastics
- New additives for polyolefins
- Useful tips for cost management
- Materials handling systems
- Simplifying EU patent legislation
January 2013 
Featuring:
- Bubbling up: new foaming agents
- The latest pelletizing systems
- Connecting with compatibilizers
- Optimizing PE foam formulations
2012
December 2012 
Featuring:
- High-temperature compounding
- Flame retardants for polyamides
- What's new in lab compounders
- Green polymer chemistry report
November 2012 
Featuring:
- Keep it clean for medical markets
- Developments in carbon black
- Stir it up with the latest mixers
- Formulating conductive HDPE
- Focus on materials testing
October 2012 
Featuring:
- Fibre reinforcements for plastics
- Trends in titanium dioxide
- Focus on screen-changers
- Fakuma 2012 show highlights
- Screw and barrel alignment
September 2012 
Featuring:
- Picking the perfect pigment
- NAFTA masterbatch trends
- Developments in mineral fillers
- How to test weather resistance
August 2012 
Featuring:
- Developments in PVC plasticizers
- Carrier materials for masterbatch
- What's new in reactive extrusion?
- Foamed plastics for lighter cars
- New attacks on fire retardants
- US and EU chemicals legislation
July 2012 
Featuring:
- Cross-linking technologies
- ERP software for compounders
- Thermoplastic elastomers
- Guide to colour measurement
- What's new in nanotubes?
- Fire retardants under attack
June 2012 
Featuring:
- Well connected: trends in cables
- Focus on medical compounding
- More top tips for twin-screws
- Giving a boost to bioplastics
- PVC additives: seeking stability
May 2012 
Featuring:
- Turn-key compounding lines
- Raising electrical conductivity
- Top tips for twin-screw extrusion
- Screeners sort out plastic pellets
- Brominated flame retardants
April 2012 
Featuring:
- Getting to grips with REACH
- New developments in antioxidants
- Understanding PP nucleation
- Improve your materials handling
- Colour trend forecasts for plastics
- Chinaplas and Plast previews
March 2012 
Featuring:
- The latest additives for PET resins
- Europe's masterbatch leaders
- New developments in pelletizers
- NPE 2012: what to see in Orlando
- Russia backs nanocomposites
February 2012 
Featuring:
- Increasing thermal conductivity
- Antimicrobials for medical devices
- Moving ahead with direct extrusion
- Focus on wood-plastic composites
- Compounds for geothermal pipes
January 2012 
Featuring:
- Developments in impact modifiers
- Compounding technology for PVC
- The latest additives for polyolefins
- Growing market demand for LFTs
- Cabot invests in graphenes
- Show time in India and Russia
2011
December 2011 
Featuring:
- Picking the right flame retardants
- Compounding in South America
- The latest laboratory extruders
- New replacements for decaBDE
- Introducing a novel FR additive
November 2011 
Featuring:
- Learning to love your gearbox
- What's new in carbon black
- Opportunities in solar power
- Automating materials testing
- Japan's revolutionary kneader
- Thermal lift for productivity
October 2011 
Featuring:
- Trends in titanium dioxide
- Focus on fibre reinforcements
- European market analysis
- Fakuma show highlights
- Developments in melt filtration

FOLLOW US ON SOCIAL
Produced by the AMI Magazines team, PlasticsWorld provides timely, concise, and editorially-independent business and technology information for anyone processing, using or buying plastics.